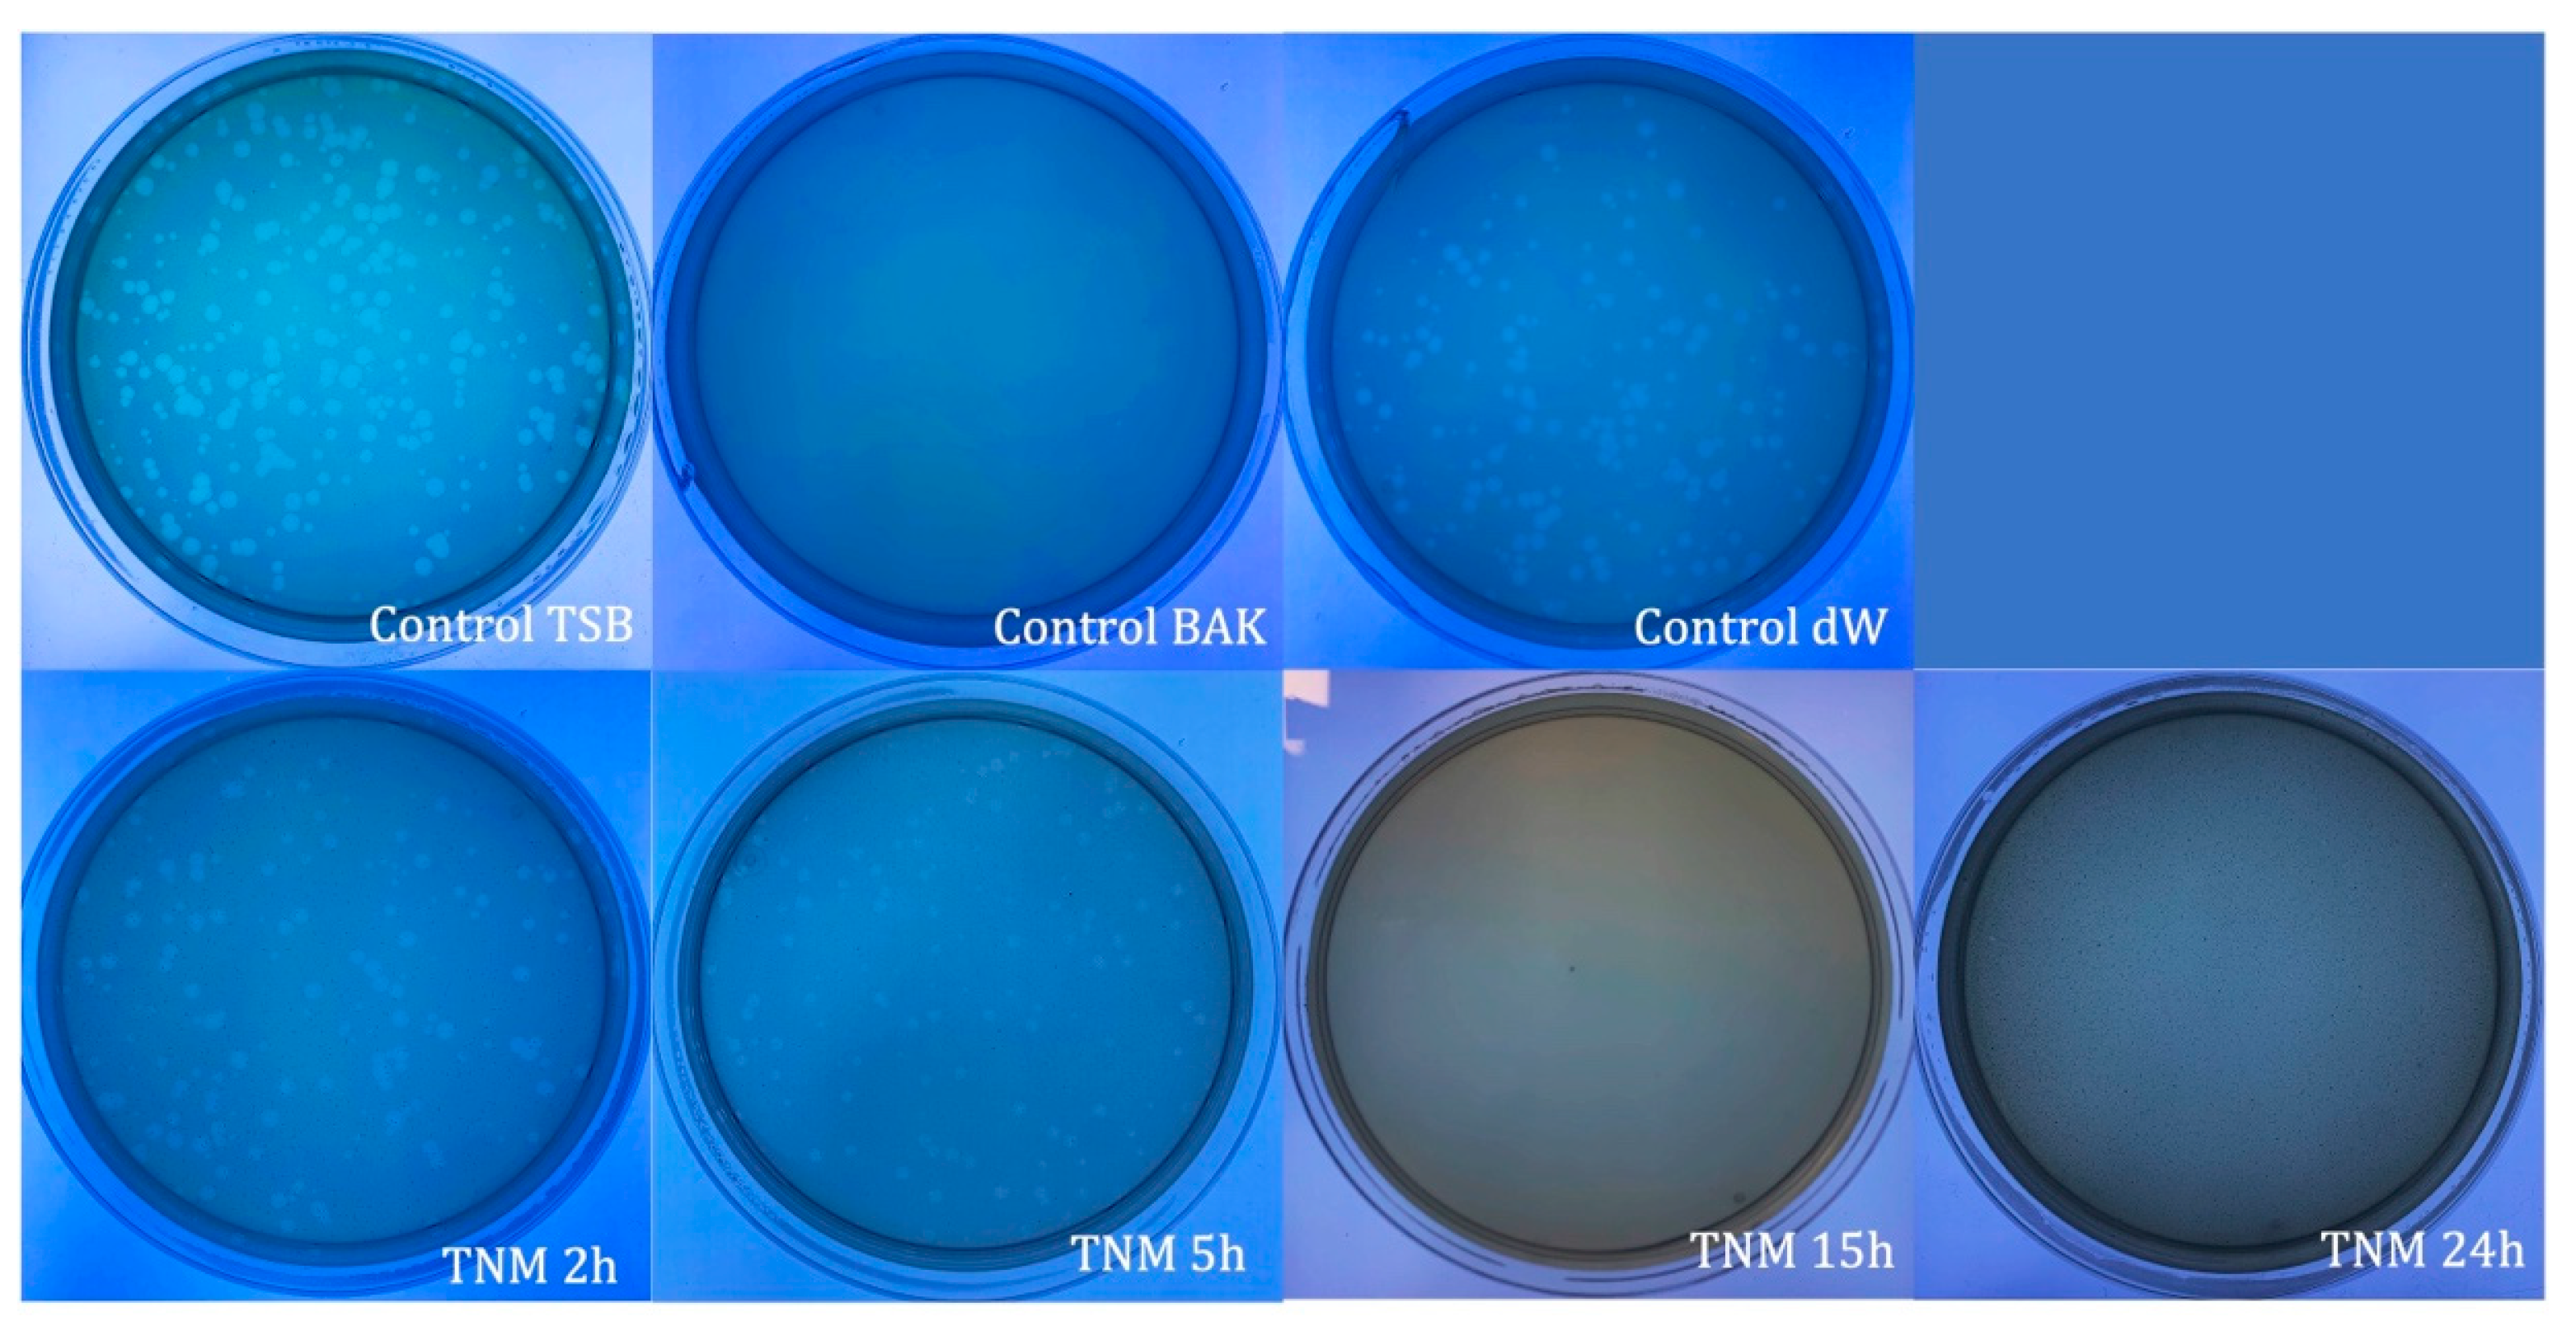
Ijms 24 12018 g001
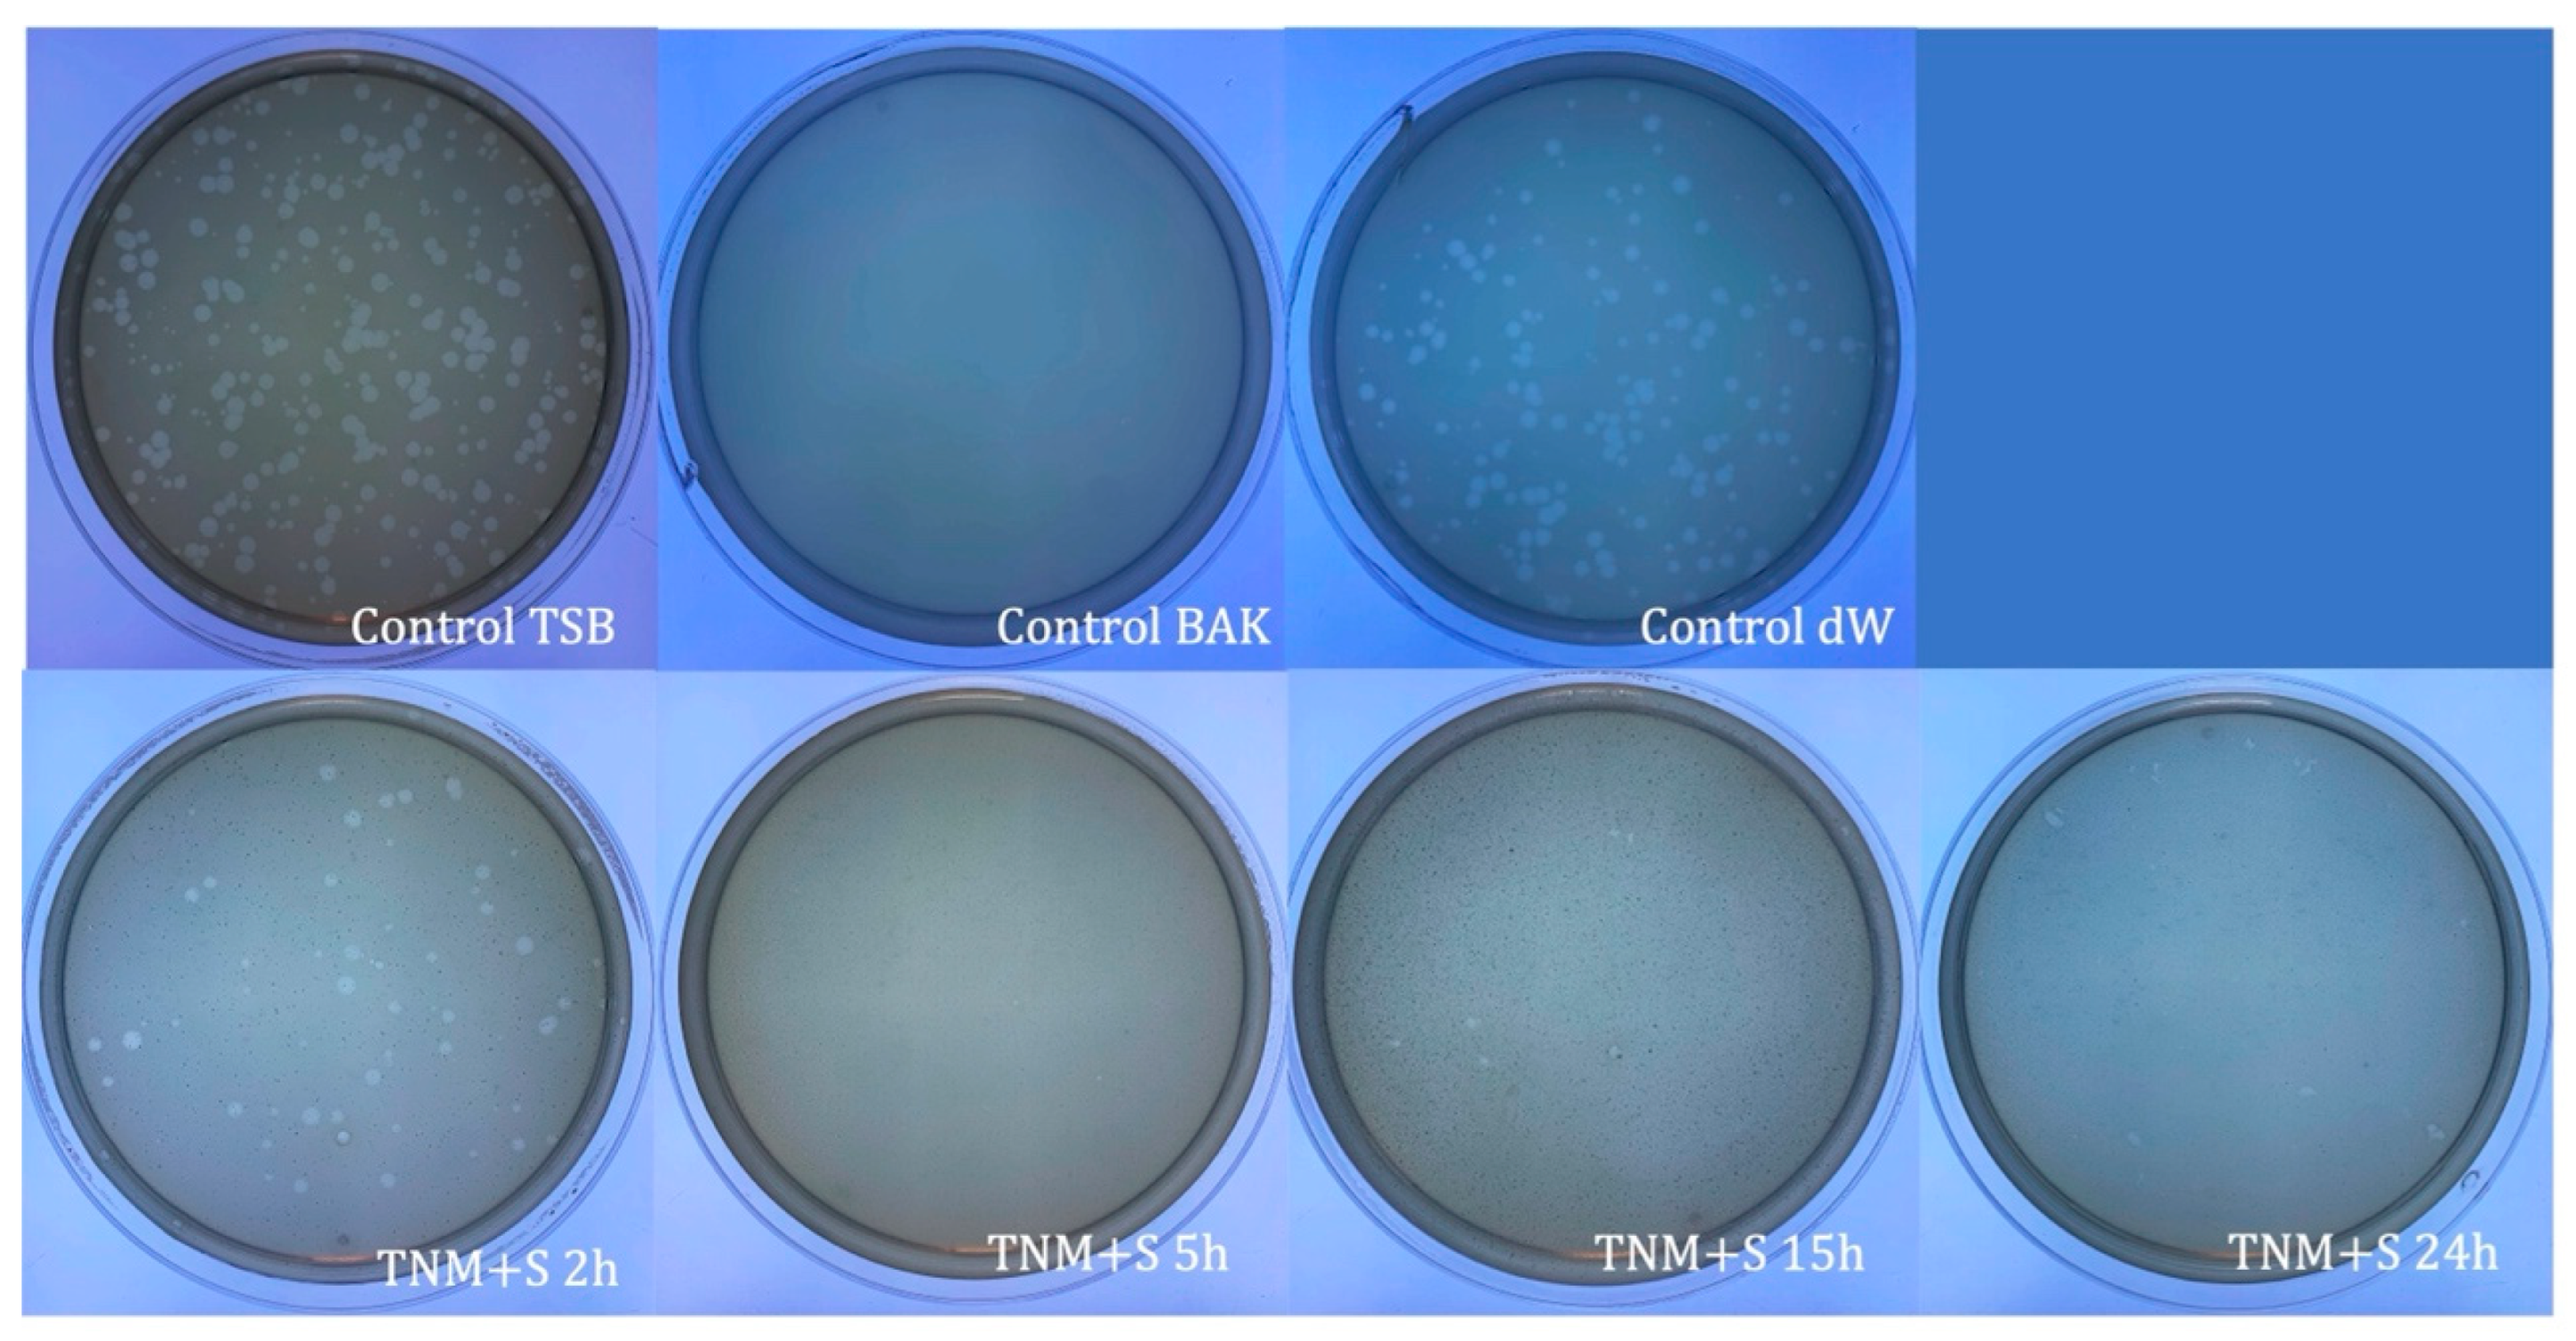
Ijms 24 12018 g002
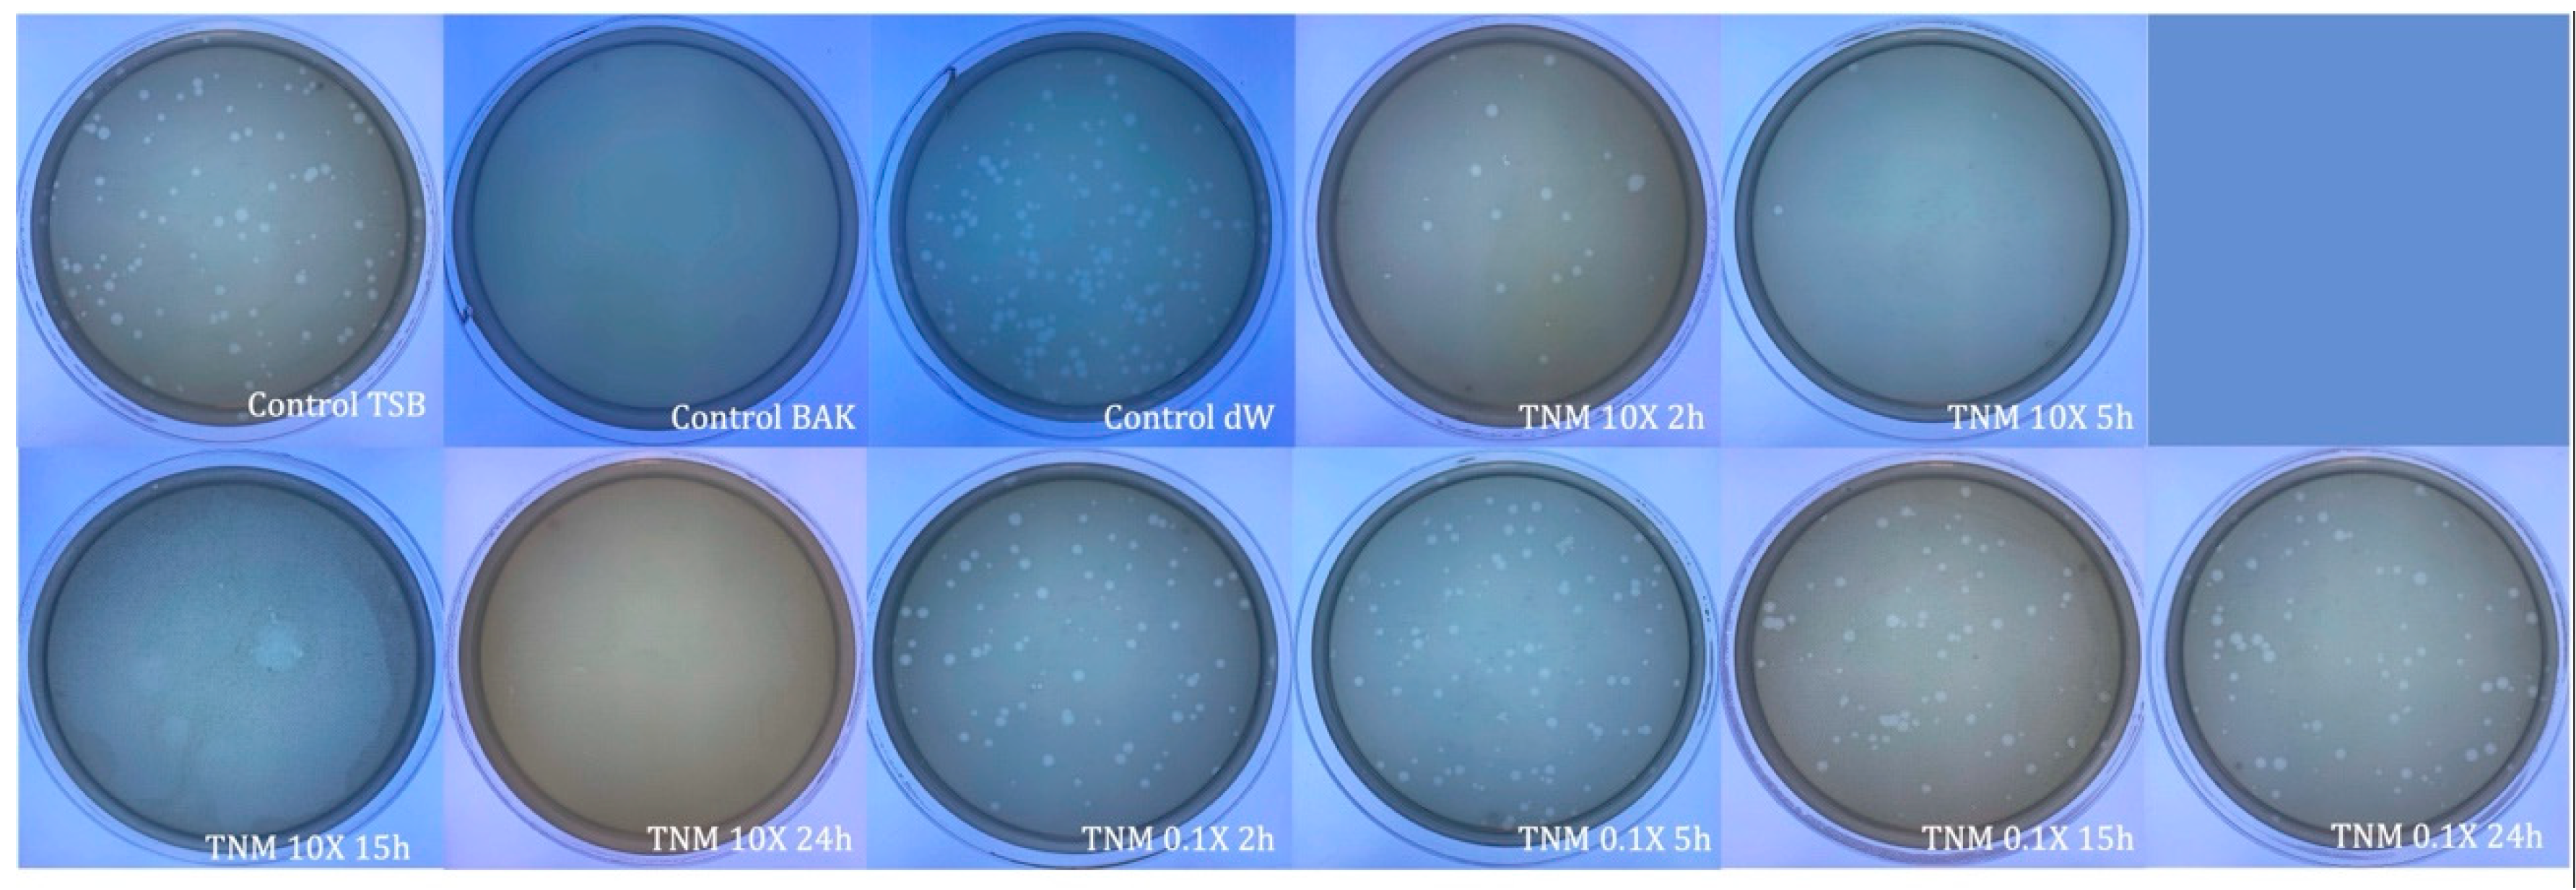
Ijms 24 12018 g004
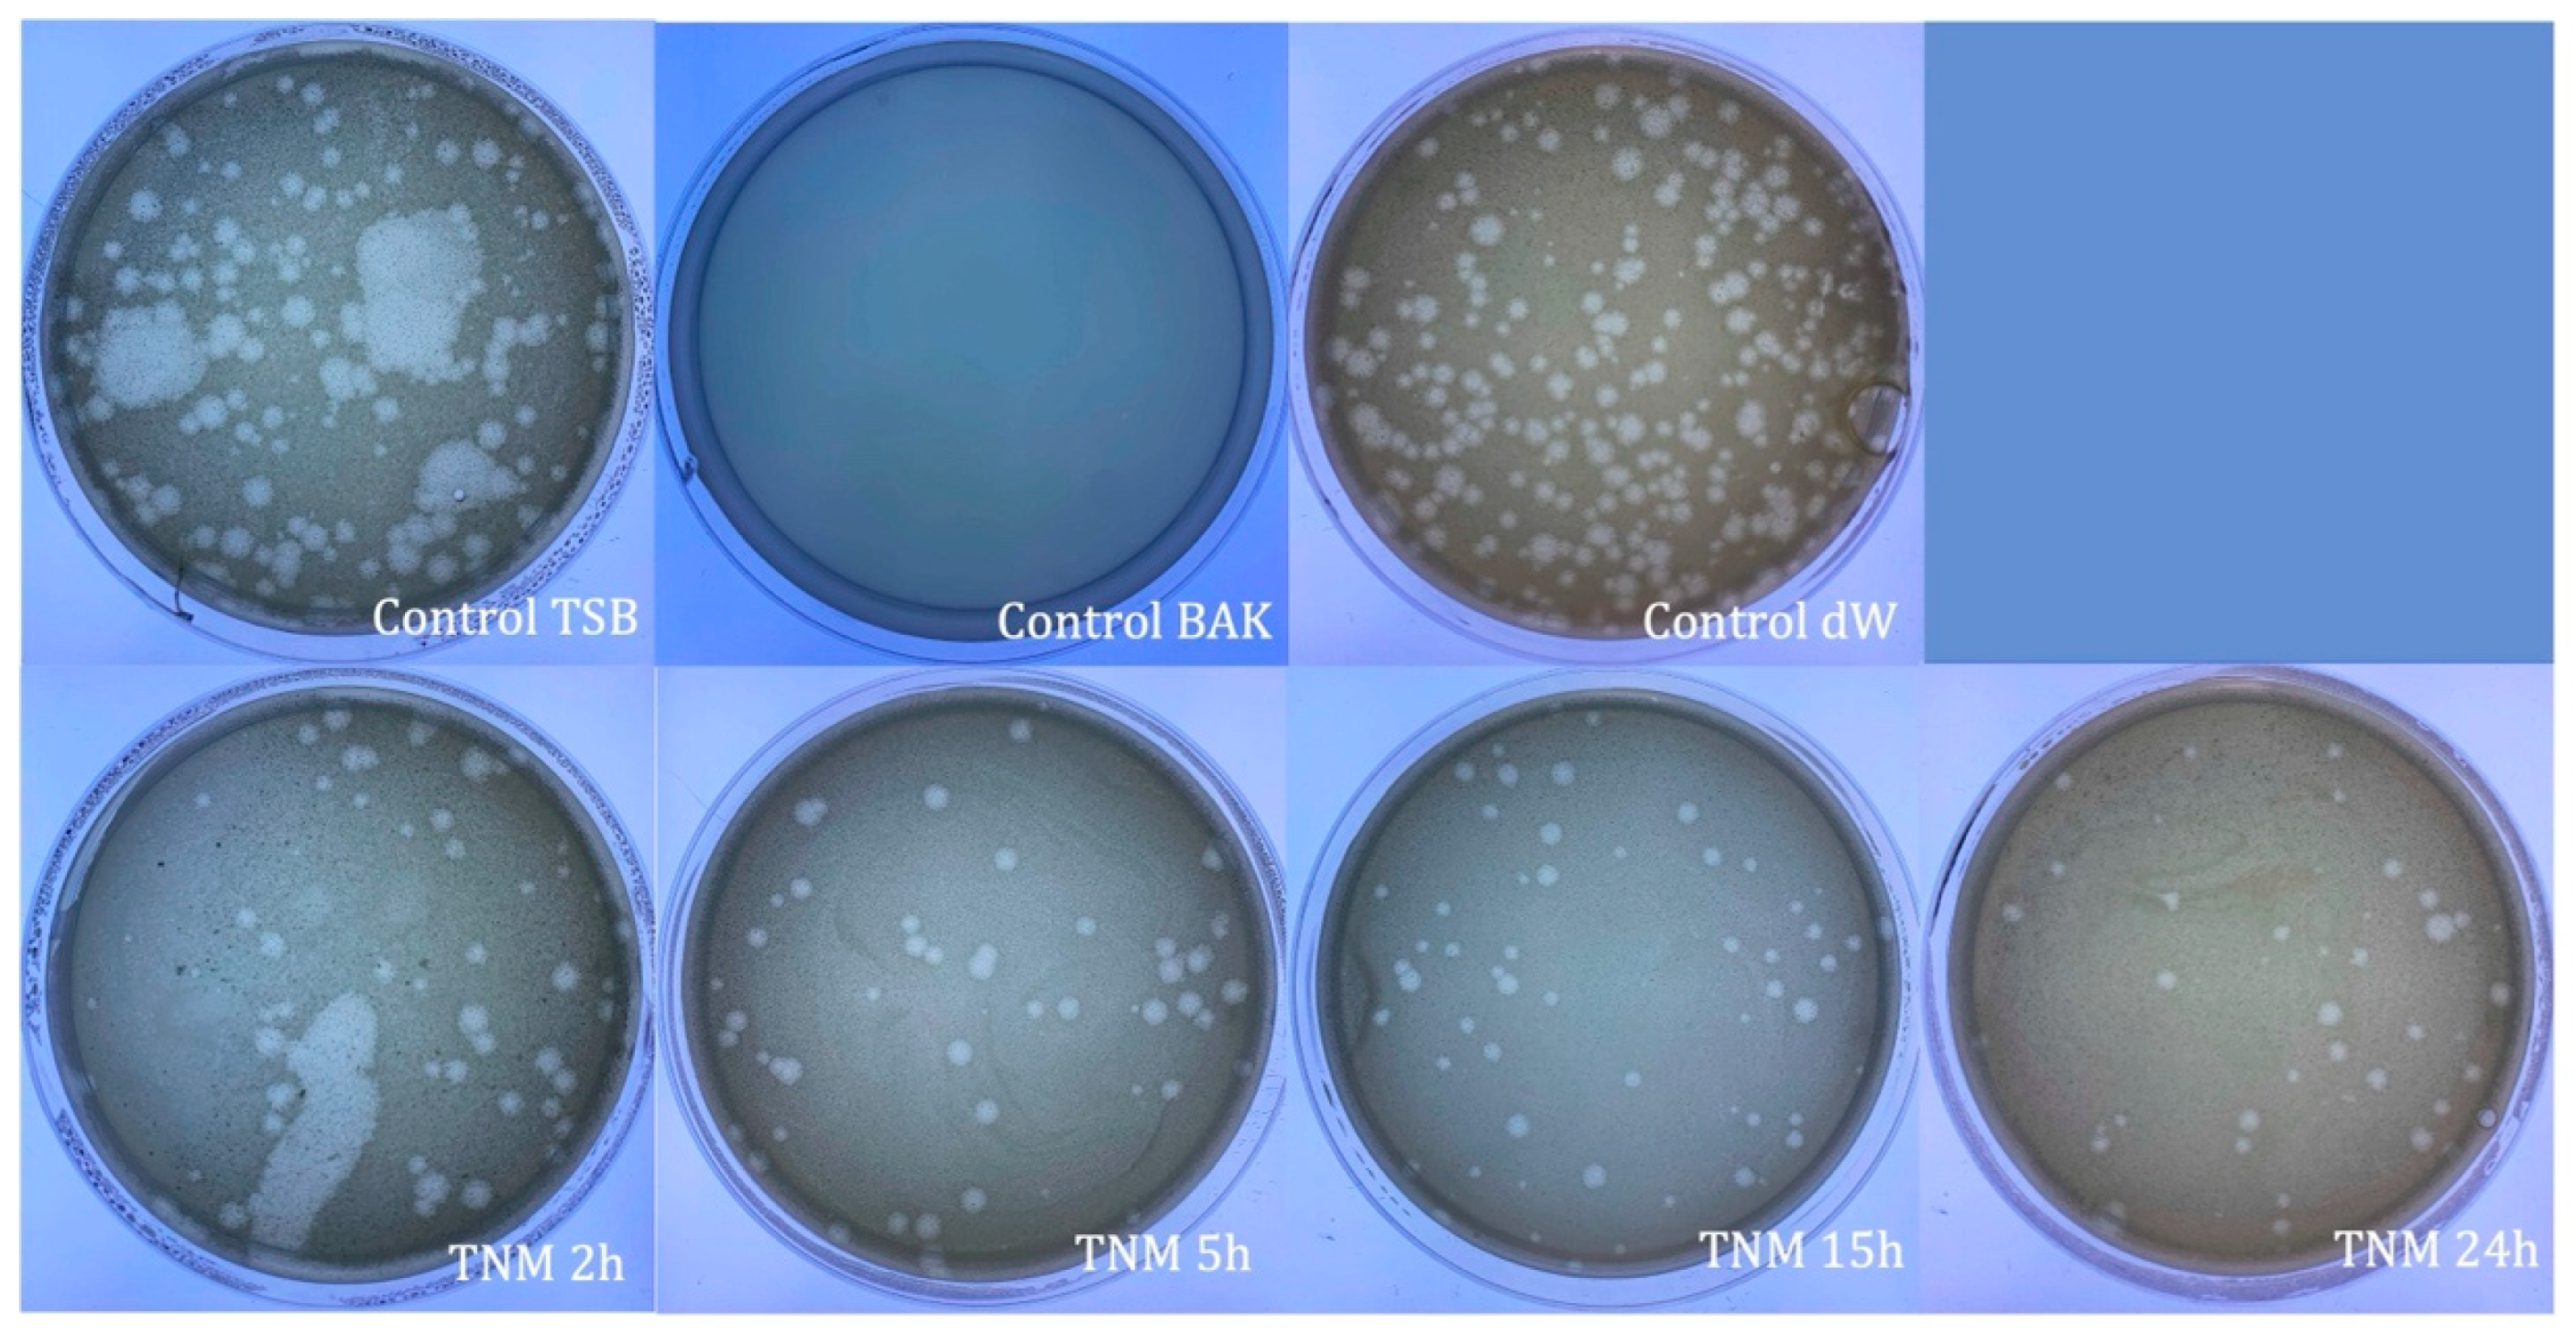
Ijms 24 12018 g006
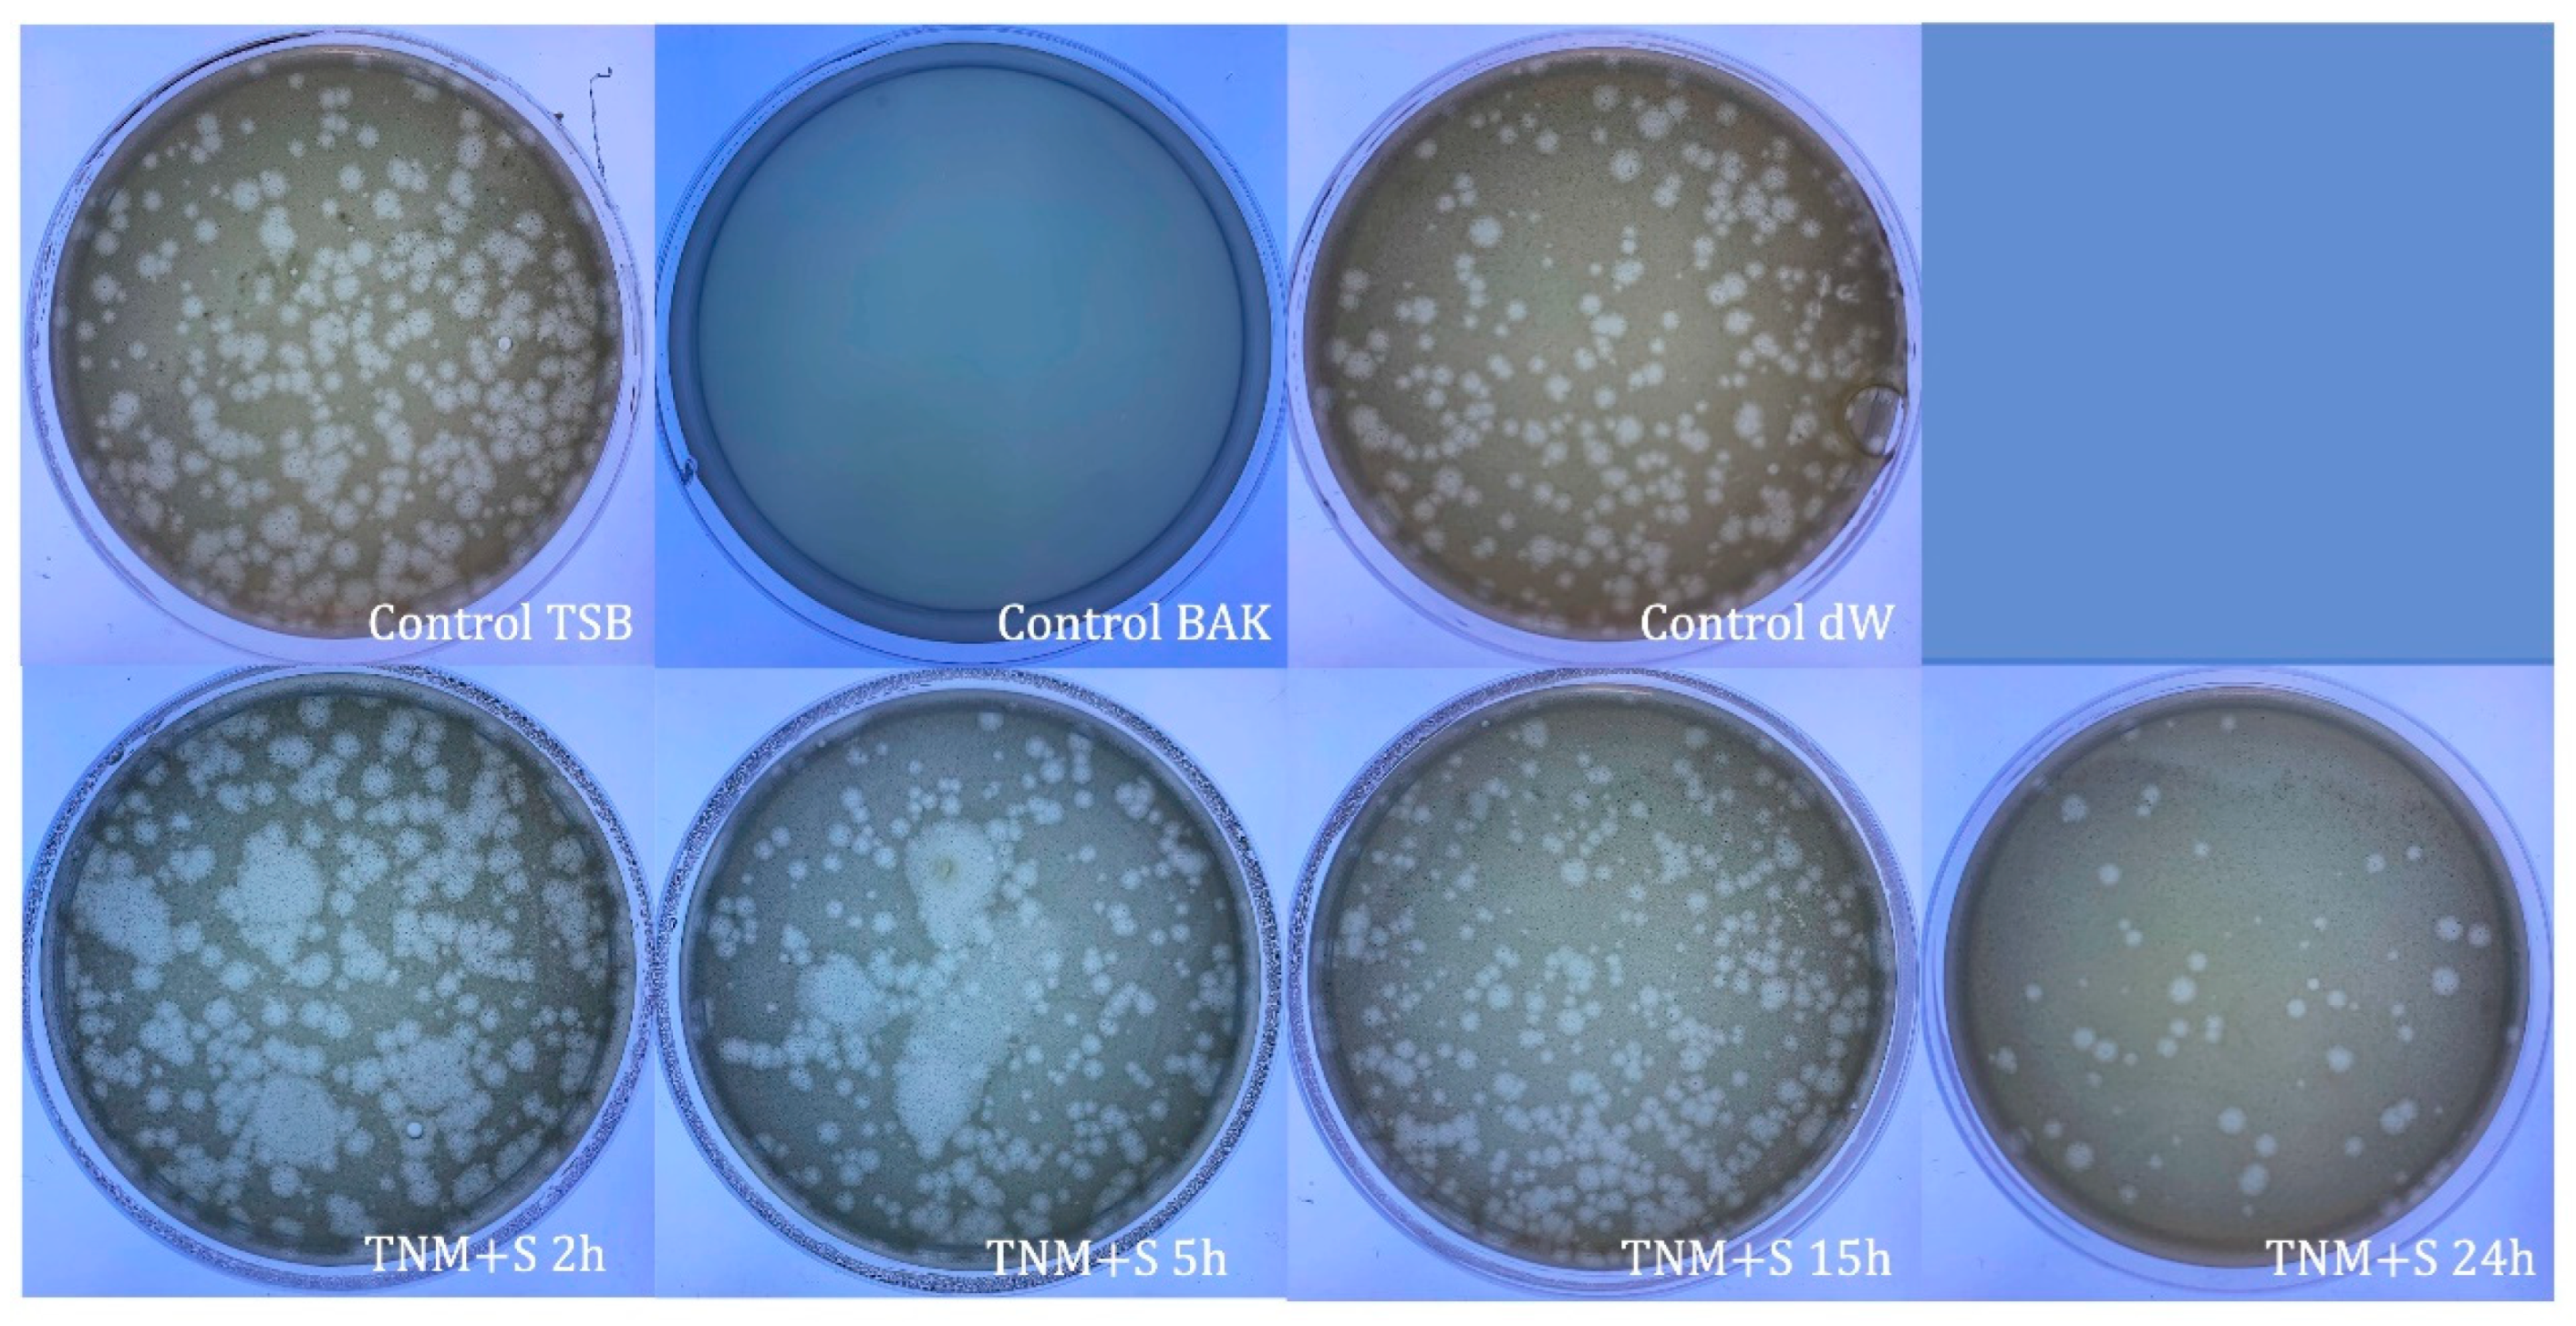
Ijms 24 12018 g008
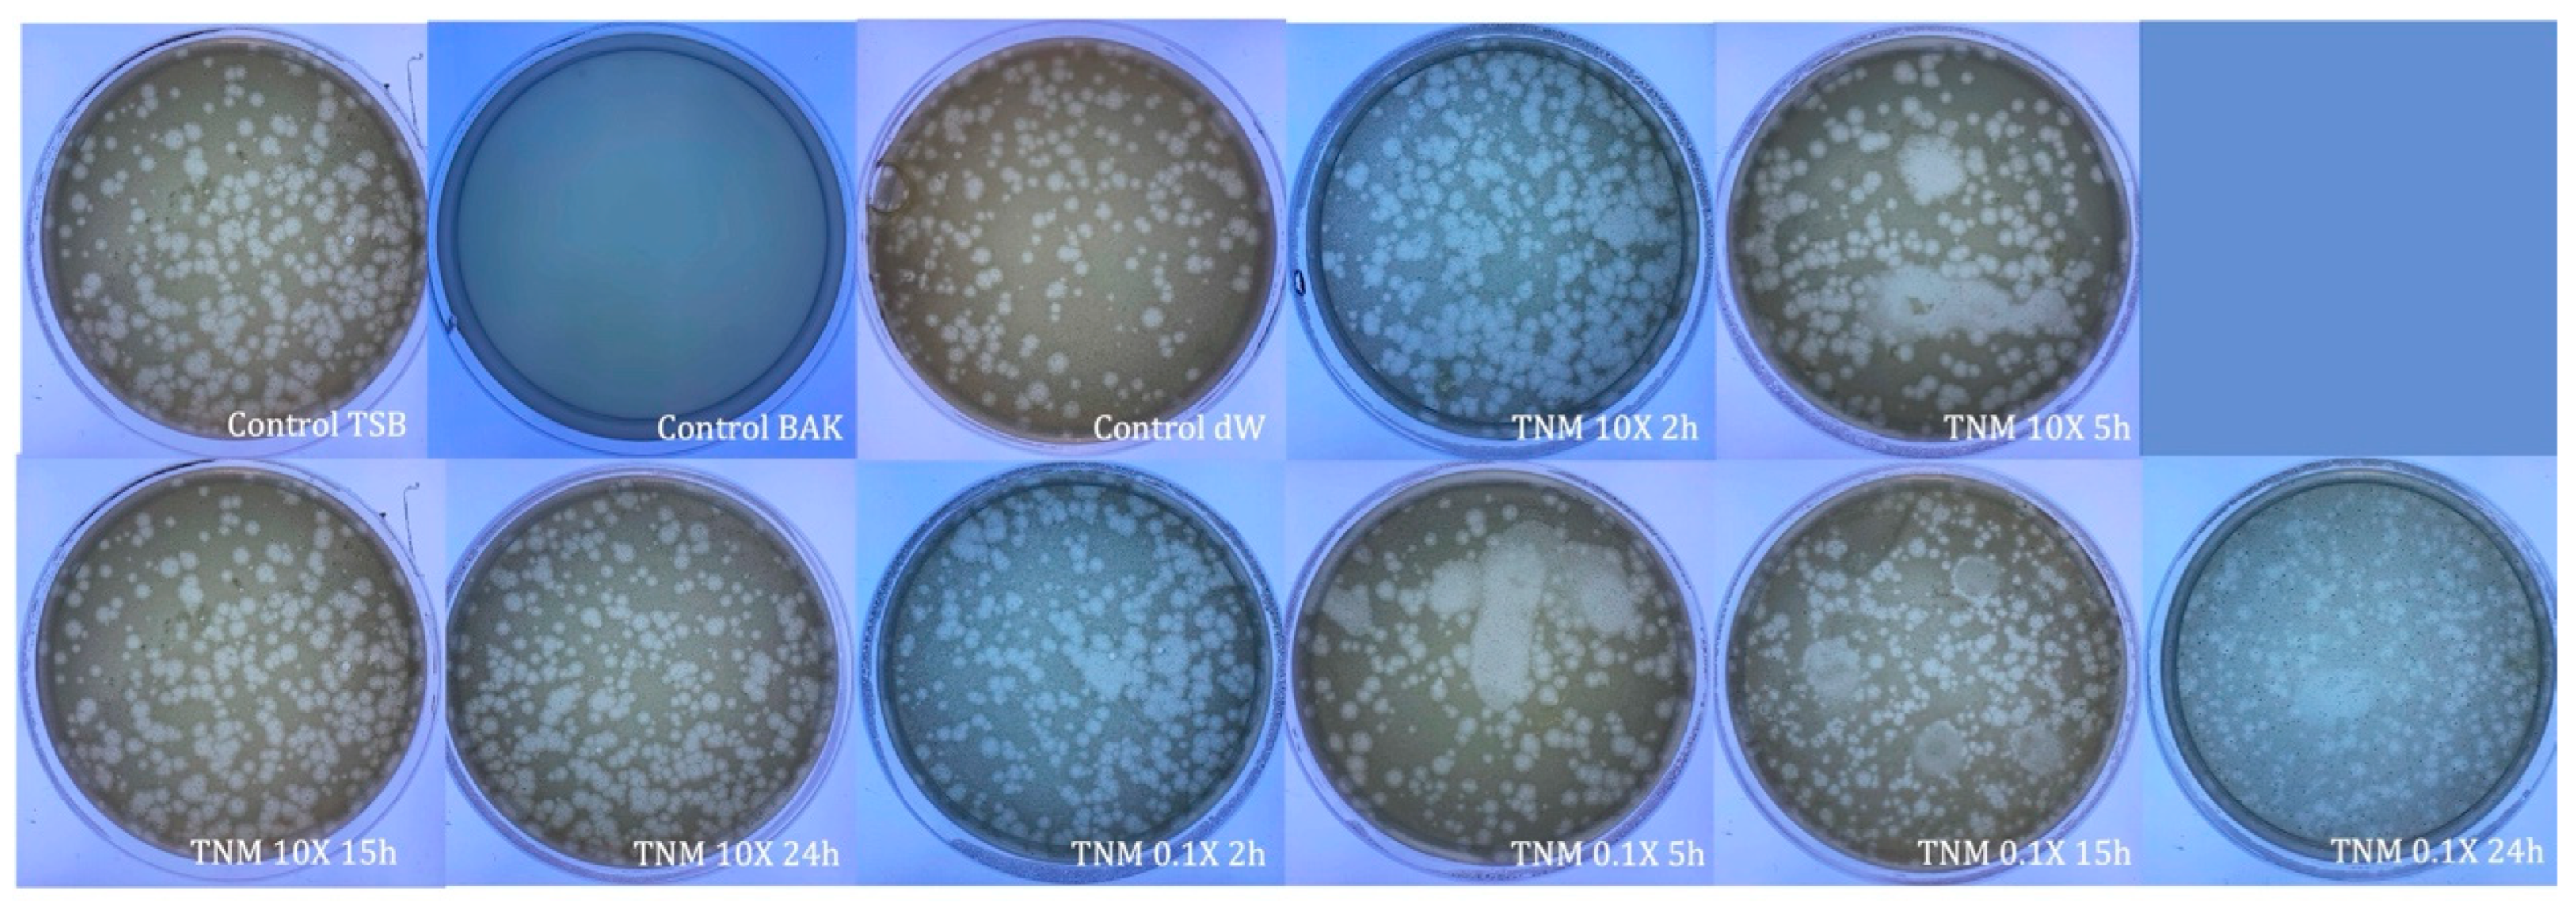
Ijms 24 12018 g010

Tiger Nut Milk’s Antiviral Properties against Enveloped and Non-Enveloped Viruses: Effect of Concentration and Adding Sugar
Abstract
1. Introduction
2. Results and Discussion
2.1. Antiviral Tests against phi 6 Bacteriophage
2.2. Antiviral Tests against Bacteriophage MS2
3. Materials and Methods
3.1. Materials
3.2. Antiviral Tests against phi 6 Bacteriophage
3.3. Antiviral Tests against MS2 Bacteriophage
3.4. Statistical Analysis
4. Conclusions
Author Contributions
Funding
Institutional Review Board Statement
Informed Consent Statement
Data Availability Statement
Acknowledgments
Conflicts of Interest
References
- Tong, T.; Hu, H.; Zhou, J.; Deng, S.; Zhang, X.; Tang, W.; Fang, L.; Xiao, S.; Liang, J. Glycyrrhizic-Acid-Based Carbon Dots with High Antiviral Activity by Multisite Inhibition Mechanisms. Small 2020, 16, e1906206. [Google Scholar] [CrossRef]
- Ashfaq, U.A.; Masoud, M.S.; Nawaz, Z.; Riazuddin, S. Glycyrrhizin as Antiviral Agent against Hepatitis C Virus. J. Transl. Med. 2011, 9, 112. [Google Scholar] [CrossRef] [PubMed]
- Cinatl, J.; Morgenstern, B.; Bauer, G.; Chandra, P.; Rabenau, H.; Doerr, H.W. Glycyrrhizin, an Active Component of Liquorice Roots, and Replication of SARS-Associated Coronavirus. Lancet 2003, 361, 2045–2046. [Google Scholar] [CrossRef] [PubMed]
- Bailly, C.; Vergoten, G. Glycyrrhizin: An Alternative Drug for the Treatment of COVID-19 Infection and the Associated Respiratory Syndrome? Pharmacol. Ther. 2020, 214, 107618. [Google Scholar] [PubMed]
- Rane, H.S.; Bernardo, S.M.; Howell, A.B.; Lee, S.A. Cranberry-Derived Proanthocyanidins Prevent Formation of Candida Albicans Biofilms in Artificial Urine through Biofilm- and Adherence-Specific Mechanisms. J. Antimicrob. Chemother. 2014, 69, 428–436. [Google Scholar] [CrossRef]
- Su, X.; Howell, A.B.; D’Souza, D.H. Antiviral Effects of Cranberry Juice and Cranberry Proanthocyanidins on Foodborne Viral Surrogates--a Time Dependence Study in Vitro. Food Microbiol. 2010, 27, 985–991. [Google Scholar] [CrossRef]
- Lipson, S.M.; Sethi, L.; Cohen, P.; Gordon, R.E.; Tan, I.P.; Burdowski, A.; Stotzky, G. Antiviral Effects on Bacteriophages and Rotavirus by Cranberry Juice. Phytomedicine 2007, 14, 23–30. [Google Scholar] [CrossRef]
- Takayama, K.; Tuñón-Molina, A.; Cano-Vicent, A.; Muramoto, Y.; Noda, T.; Aparicio-Collado, J.L.; Sabater I Serra, R.; Martí, M.; Serrano-Aroca, Á. Non-Woven Infection Prevention Fabrics Coated with Biobased Cranberry Extracts Inactivate Enveloped Viruses Such as SARS-CoV-2 and Multidrug-Resistant Bacteria. Int. J. Mol. Sci. 2021, 22, 12719. [Google Scholar] [CrossRef]
- Da Costa Neto, J.J.G.; Gomes, T.L.M.; Justo, T.F.; Pereira, K.S.; Amaral, P.F.F.; Rocha Leão, M.H.M.; Fontes Sant’Ana, G.C. Microencapsulation of Tiger Nut Milk by Lyophilization: Morphological Characteristics, Shelf Life and Microbiological Stability. Food Chem. 2019, 284, 133–139. [Google Scholar] [CrossRef]
- Selma-Royo, M.; García-Mantrana, I.; Collado, M.C.; Perez-Martínez, G. Intake of Natural, Unprocessed Tiger Nuts (Cyperus Esculentus L.) Drink Significantly Favors Intestinal Beneficial Bacteria in a Short Period of Time. Nutrients 2022, 14, 1709. [Google Scholar] [CrossRef]
- Chukwuma, E.R.; Obioma, N.; Christopher, O.I. The Phytochemical Composition and Some Biochemical Effects of Nigerian Tigernut (Cyperus Esculentus L.) Tuber. Pak. J. Nutr. 2010, 9, 709–715. [Google Scholar] [CrossRef]
- Sánchez-Zapata, E.; Fernández-López, J.; Angel Pérez-Alvarez, J. Tiger Nut (Cyperus Esculentus) Commercialization: Health Aspects, Composition, Properties, and Food Applications. Compr. Rev. Food Sci. Food Saf. 2012, 11, 366–377. [Google Scholar] [CrossRef]
- Adejuyitan, J.A.; Otunola, E.T.; Akande, E.A.; Bolarinwa, I.F.; Oladokun, F.M. Some Physicochemical Properties of Flour Obtained from Fermentation of Tigernut (Cyperus Esculentus) Sourced from a Market in Ogbomoso, Nigeria. Afr. J. Food Sci. 2009, 3, 51–55. [Google Scholar]
- Falcó, I.; Randazzo, W.; Rodríguez-Díaz, J.; Gozalbo-Rovira, R.; Luque, D.; Aznar, R.; Sánchez, G. Antiviral Activity of Aged Green Tea Extract in Model Food Systems and under Gastric Conditions. Int. J. Food Microbiol. 2019, 292, 101–106. [Google Scholar] [CrossRef] [PubMed]
- Nwosu, L.C.; Edo, G.I.; Özgör, E. The Phytochemical, Proximate, Pharmacological, GC-MS Analysis of Cyperus Esculentus (Tiger Nut): A Fully Validated Approach in Health, Food and Nutrition. Food Biosci. 2022, 46, 101551. [Google Scholar] [CrossRef]
- Serrano-Aroca, Á. Antiviral Characterization of Advanced Materials: Use of Bacteriophage Phi 6 as Surrogate of Enveloped Viruses Such as SARS-CoV-2. Int. J. Mol. Sci. 2022, 23, 5335. [Google Scholar] [CrossRef]
- Tejera, E.; Pérez-Castillo, Y.; Toscano, G.; Noboa, A.L.; Ochoa-Herrera, V.; Giampieri, F.; Álvarez-Suarez, J.M. Computational Modeling Predicts Potential Effects of the Herbal Infusion “Horchata” against COVID-19. Food Chem. 2022, 366, 130589. [Google Scholar] [CrossRef]
- Chang, J.; Wang, L.; Ma, D.; Qu, X.; Guo, H.; Xu, X.; Mason, P.M.; Bourne, N.; Moriarty, R.; Gu, B.; et al. Novel Imino Sugar Derivatives Demonstrate Potent Antiviral Activity against Flaviviruses. Antimicrob. Agents Chemother. 2009, 53, 1501–1508. [Google Scholar] [CrossRef]
- Howe, J.D.; Smith, N.; Lee, M.J.R.; Ardes-Guisot, N.; Vauzeilles, B.; Désiré, J.; Baron, A.; Blériot, Y.; Sollogoub, M.; Alonzi, D.S.; et al. Novel Imino Sugar α-Glucosidase Inhibitors as Antiviral Compounds. Bioorganic Med. Chem. 2013, 21, 4831–4838. [Google Scholar] [CrossRef]
- Kifli, N.; Htar, T.T.; De Clercq, E.; Balzarini, J.; Simons, C. Novel Bicyclic Sugar Modified Nucleosides: Synthesis, Conformational Analysis and Antiviral Evaluation. Bioorganic Med. Chem. 2004, 12, 3247–3257. [Google Scholar] [CrossRef]
- Sanmartín-Santos, I.; Gandía-Llop, S.; Salesa, B.; Martí, M.; Lillelund Aachmann, F.; Serrano-Aroca, Á. Enhancement of Antimicrobial Activity of Alginate Films with a Low Amount of Carbon Nanofibers (0.1% w/w). Appl. Sci. 2021, 11, 2311. [Google Scholar] [CrossRef]
- Yu, Y.; Lu, X.; Zhang, T.; Zhao, C.; Guan, S.; Pu, Y.; Gao, F. Tiger Nut (Cyperus Esculentus L.): Nutrition, Processing, Function and Applications. Foods 2022, 11, 601. [Google Scholar] [CrossRef]
- Johari, J.; Kianmehr, A.; Mustafa, M.R.; Abubakar, S.; Zandi, K. Antiviral Activity of Baicalein and Quercetin against the Japanese Encephalitis Virus. Int. J. Mol. Sci. 2012, 13, 16785–16795. [Google Scholar] [CrossRef]
- Cushnie, T.P.T.; Lamb, A.J. Antimicrobial Activity of Flavonoids. Int. J. Antimicrob. Agents 2005, 26, 343–356. [Google Scholar] [CrossRef]
- Ramos, F.A.; Takaishi, Y.; Shirotori, M.; Kawaguchi, Y.; Tsuchiya, K.; Shibata, H.; Higuti, T.; Tadokoro, T.; Takeuchi, M. Antibacterial and Antioxidant Activities of Quercetin Oxidation Products from Yellow Onion (Allium Cepa) Skin. J. Agric. Food Chem. 2006, 54, 3551–3557. [Google Scholar] [CrossRef]
- Sharma, K.; Ko, E.Y.; Assefa, A.D.; Ha, S.; Nile, S.H.; Lee, E.T.; Park, S.W. Temperature-Dependent Studies on the Total Phenolics, Flavonoids, Antioxidant Activities, and Sugar Content in Six Onion Varieties. J. Food Drug Anal. 2015, 23, 243–252. [Google Scholar] [CrossRef]
- Tuñón-Molina, A.; Cano-Vicent, A.; Serrano-Aroca, Á. Antimicrobial Lipstick: Bio-Based Composition against Viruses, Bacteria, and Fungi. ACS Appl. Mater. Interfaces 2022, 14, 56658–56665. [Google Scholar] [CrossRef] [PubMed]
- Kropinski, A.M.; Mazzocco, A.; Waddell, T.E.; Lingohr, E.; Johnson, R.P. Enumeration of Bacteriophages by Double Agar Overlay Plaque Assay. In Bacteriophages; Methods in Molecular Biology; Springer: Berlin/Heidelberg, Germany, 2009; Volume 501, pp. 69–76. [Google Scholar] [CrossRef]
- Martí, M.; Tuñón-Molina, A.; Aachmann, F.L.; Muramoto, Y.; Noda, T.; Takayama, K.; Serrano-Aroca, Á. Protective Face Mask Filter Capable of Inactivating SARS-CoV-2, and Methicillin-Resistant Staphylococcus Aureus and Staphylococcus Epidermidis. Polymers 2021, 13, 207. [Google Scholar] [CrossRef] [PubMed]
- Tuñón-Molina, A.; Martí, M.; Muramoto, Y.; Noda, T.; Takayama, K.; Serrano-Aroca, Á. Antimicrobial Face Shield: Next Generation of Facial Protective Equipment against SARS-CoV-2 and Multidrug-Resistant Bacteria. Int. J. Mol. Sci. 2021, 22, 9518. [Google Scholar] [CrossRef] [PubMed]

| SAMPLE | VIRUS CONCENTRATION (PFU/mL) | Log10 REDUCTION | VIRAL INACTIVATION (%) |
|---|---|---|---|
| control TSB | 4.96 × 106 ± 4.53 × 105 | - | - |
| control BAK | 0.00 ± 0.00 | ~7 | 100 |
| control dW | 3.11 × 106 ± 3.72 × 105 | ~0 | ~0 |
| TNM 2h | 3.01 × 106 ± 6.52 × 105 | ~0 | ~0 |
| TNM 5h | 3.21 × 106 ± 1.97 × 105 | ~0 | ~0 |
| TNM 15h | 0.00 ± 0.00 | ~7 | 100 |
| TNM 24h | 0.00 ± 0.00 | ~7 | 10 |
| SAMPLE | VIRUS CONCENTRATION (PFU/mL) | Log10 REDUCTION | VIRAL INACTIVATION (%) |
|---|---|---|---|
| control TSB | 2.37 × 106 ± 5.33 × 105 | - | - |
| control BAK | 0.00 ± 0.00 | ~6 | 100 |
| control dW | 3.10 × 106 ± 8.77 × 105 | ~0 | ~0 |
| TNM+S 2h | 1.57 × 106 ± 1.22 × 105 | ~0 | ~0 |
| TNM+S 5h | 0.00 ± 0.00 | ~6 | 100 |
| TNM+S 15h | 0.00 ± 0.00 | ~6 | 100 |
| TNM+S 24h | 0.00 ± 0.00 | ~6 | 100 |
| SAMPLE | VIRUS CONCENTRATION (PFU/mL) | Log10 REDUCTION | VIRAL INACTIVATION (%) |
|---|---|---|---|
| control TSB | 2.04 × 106 ± 2.83 × 105 | - | - |
| control BAK | 0.00 ± 0.00 | ~6 | 100 |
| control dW | 3.43 × 106 ± 1.84 × 105 | ~0 | ~0 |
| TNM 10X 2h | 2.69 × 105 ± 7.26 × 104 | ~1 | ~87 |
| TNM 10X 5h | 9.13 × 104 ± 8.72 × 104 | ~2 | ~96 |
| TNM 10X 15h | 2.67 × 103 ± 3.06 × 103 | ~3 | ~100 |
| TNM 10X 24h | 8.67 × 103 ± 6.11 × 103 | ~3 | ~100 |
| TNM 0.1X 2h | 1.92 × 106 ± 2.88 × 105 | ~0 | ~0 |
| TNM 0.1X 5h | 2.43 × 106 ± 1.67 × 105 | ~0 | ~0 |
| TNM 0.1X 15h | 4.87 × 105 ± 1.30 × 105 | ~0.5 | ~76 |
| TNM 0.1X 24h | 2.21 × 106 ± 3.03 × 105 | ~0 | ~0 |
| SAMPLE | VIRUS CONCENTRATION (PFU/mL) | Log10 REDUCTION | VIRAL INACTIVATION (%) |
|---|---|---|---|
| control TSB | 4.40 × 107 ± 5.66 × 106 | - | - |
| control BAK | 0.00 ± 0.00 | ~8 | 100 |
| control dW | 2.17 × 107 ± 6.23 × 106 | ~0 | ~0 |
| TNM 2h | 1.31 × 107 ± 9.45 × 105 | ~0 | ~0 |
| TNM 5h | 1.11 × 107 ± 1.21 × 106 | ~0 | ~0 |
| TNM 15h | 9.27 × 106 ± 2.21 × 106 | ~0 | ~0 |
| TNM 24h | 6.80 × 107 ± 6.93 × 106 | ~0 | ~0 |
| SAMPLE | VIRUS CONCENTRATION (PFU/mL) | Log10 REDUCTION | VIRAL INACTIVATION (%) |
|---|---|---|---|
| control TSB | 1.54 × 108 ± 1.41 × 107 | - | - |
| control BAK | 0.00 ± 0.00 | ~8 | 100 |
| control dW | 2.17 × 108 ± 6.23 × 107 | ~0 | ~0 |
| TNM+S 2h | 7.47 × 108 ± 6.11 × 107 | ~0 | ~0 |
| TNM+S 5h | 1.14 × 108 ± 4.06 × 107 | ~0 | ~0 |
| TNM+S 15h | 1.17 × 108 ± 1.92 × 107 | ~0 | ~0 |
| TNM+S 24h | 3.23 × 107 ± 4.41 × 106 | ~1 | ~79 |
| SAMPLE | VIRUS CONCENTRATION (PFU/mL) | Log10 REDUCTION | VIRAL INACTIVATION (%) |
|---|---|---|---|
| control TSB | 2.64 × 107 ± 1.13 × 106 | - | - |
| control BAK | 0.00 ± 0.00 | ~7 | 100 |
| control dW | 5.64 × 107 ± 2.34 × 106 | ~0 | ~0 |
| TNM 10X 2h | 1.44 × 107 ± 2.31 × 106 | ~0 | ~0 |
| TNM 10X 5h | 8.47 × 106 ± 3.88 × 106 | ~0 | ~0 |
| TNM 10X 15h | 1.15 × 107 ± 2.19 × 106 | ~0 | ~0 |
| TNM 10X 24h | 8.85 × 107 ± 4.69 × 106 | ~0 | ~0 |
| TNM 0.1X 2h | 1.36 × 107 ± 1.51 × 106 | ~0 | ~0 |
| TNM 0.1X 5h | 3.18 × 107 ± 1.39 × 107 | ~0 | ~0 |
| TNM 0.1X 15h | 1.05 × 107 ± 1.22 × 106 | ~0 | ~0 |
| TNM 0.1X 24h | 8.13 × 107 ± 4.69 × 106 | ~0 | ~0 |
Disclaimer/Publisher’s Note: The statements, opinions and data contained in all publications are solely those of the individual author(s) and contributor(s) and not of MDPI and/or the editor(s). MDPI and/or the editor(s) disclaim responsibility for any injury to people or property resulting from any ideas, methods, instructions or products referred to in the content. |
© 2023 by the authors. Licensee MDPI, Basel, Switzerland. This article is an open access article distributed under the terms and conditions of the Creative Commons Attribution (CC BY) license (https://creativecommons.org/licenses/by/4.0/).
Share and Cite
Tuñón-Molina, A.; Cano-Vicent, A.; Serrano-Aroca, Á. Tiger Nut Milk’s Antiviral Properties against Enveloped and Non-Enveloped Viruses: Effect of Concentration and Adding Sugar. Int. J. Mol. Sci. 2023, 24, 12018. https://doi.org/10.3390/ijms241512018
Tuñón-Molina A, Cano-Vicent A, Serrano-Aroca Á. Tiger Nut Milk’s Antiviral Properties against Enveloped and Non-Enveloped Viruses: Effect of Concentration and Adding Sugar. International Journal of Molecular Sciences. 2023; 24(15):12018. https://doi.org/10.3390/ijms241512018
Chicago/Turabian StyleTuñón-Molina, Alberto, Alba Cano-Vicent, and Ángel Serrano-Aroca. 2023. "Tiger Nut Milk’s Antiviral Properties against Enveloped and Non-Enveloped Viruses: Effect of Concentration and Adding Sugar" International Journal of Molecular Sciences 24, no. 15: 12018. https://doi.org/10.3390/ijms241512018
APA StyleTuñón-Molina, A., Cano-Vicent, A., & Serrano-Aroca, Á. (2023). Tiger Nut Milk’s Antiviral Properties against Enveloped and Non-Enveloped Viruses: Effect of Concentration and Adding Sugar. International Journal of Molecular Sciences, 24(15), 12018. https://doi.org/10.3390/ijms241512018

